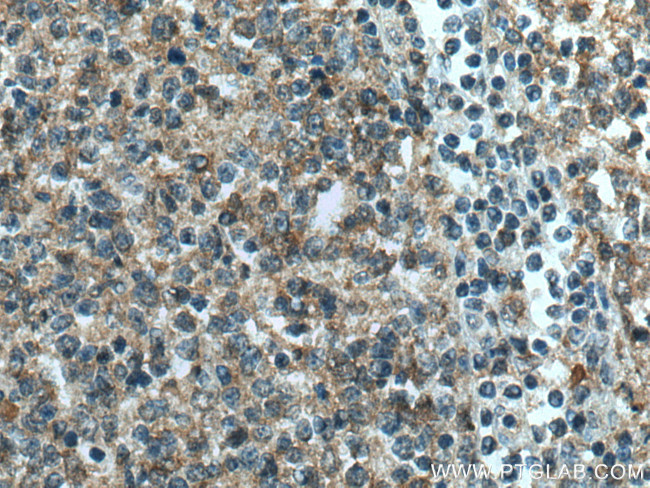
IL-4R Antibody in Immunohistochemistry (Paraffin) (IHC (P))

Search
Proteintech
IL-4R Polyclonal Antibody
{{$productOrderCtrl.translations['antibody.pdp.commerceCard.promotion.promotions']}}
{{$productOrderCtrl.translations['antibody.pdp.commerceCard.promotion.viewpromo']}}
{{$productOrderCtrl.translations['antibody.pdp.commerceCard.promotion.promocode']}}: {{promo.promoCode}} {{promo.promoTitle}} {{promo.promoDescription}}. {{$productOrderCtrl.translations['antibody.pdp.commerceCard.promotion.learnmore']}}
产品信息
28331-1-AP
种属反应
宿主/亚型
分类
类型
抗原
偶联物
形式
浓度
规格
纯化类型
保存液
内含物
保存条件
运输条件
产品详细信息
Aliquoting is unnecessary for -20°C storage.
靶标信息
IL4 Receptor alpha (IL4RA) is the alpha chain of the interleukin 4 receptor which binds to both interleukin 4 and interleukin 13 to regulate IgE production, chemokine and mucus production at sites of allergic inflammmation. The IL4 response is involved in promoting Th2 differentiation. The secreted extracellular domain of IL4R alpha, called sIL4R alpha, can inhibit IL4-mediated cell proliferation and IL5 upregulation by T-cells. It has no signaling abilities. Allelic variations in the IL4RA gene have been associated with atopy, a condition that can manifest itself as allergic rhinitis, sinusitus, asthma, or eczema.
仅用于科研。不用于诊断过程。未经明确授权不得转售。
生物信息学
蛋白别名: CD124; il-4 receptor; IL-4 receptor subunit alpha; IL4Ra; interleukin 13 receptor; interleukin-4 receptor alpha chain; Interleukin-4 receptor subunit alpha; unnamed protein product
基因别名: 582J2.1; CD124; IL-4RA; IL4R; IL4RA
UniProt ID: (Human) P24394
Entrez Gene ID: (Human) 3566